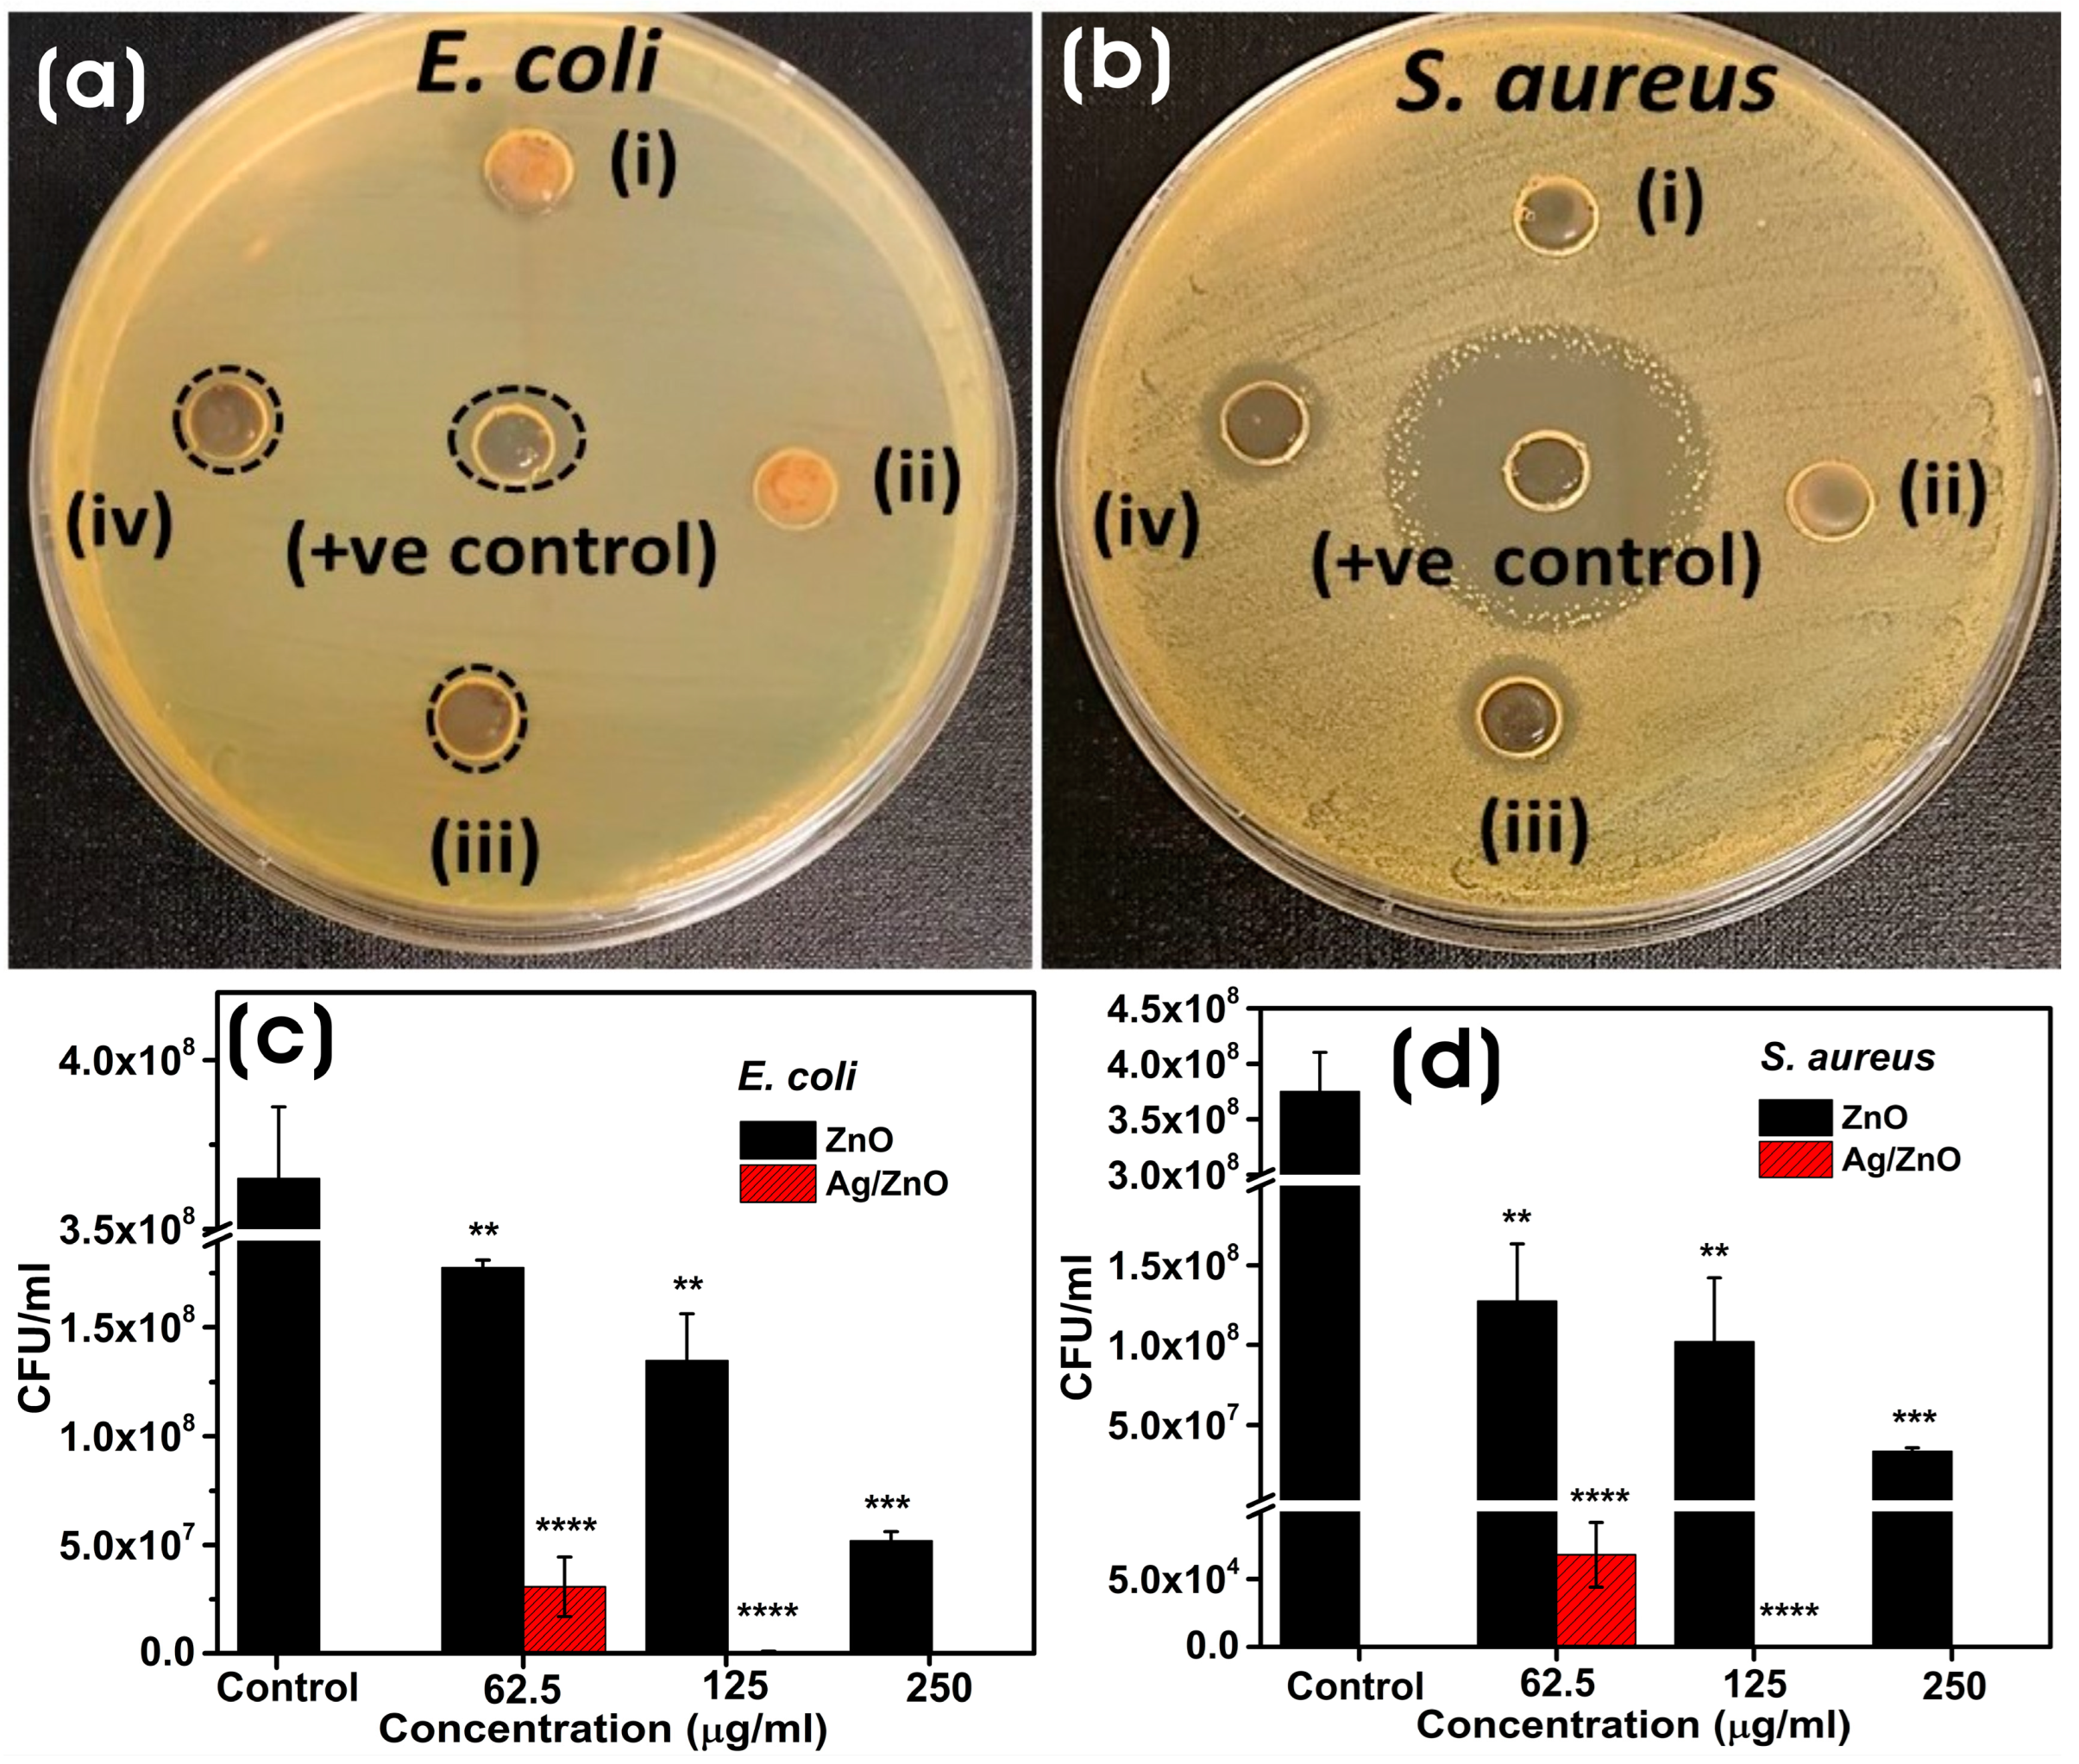
Microorganisms 11 01810 g008

Photocatalytic Degradation, Anticancer, and Antibacterial Studies of Lysinibacillus sphaericus Biosynthesized Hybrid Metal/Semiconductor Nanocomposites
Abstract
1. Introduction
2. Materials
2.1. Culturing of the Lysinibacillus sphaericus Bacterium
2.2. Biosynthesis of Semiconductor and Metal/Semiconductor NCs
2.3. Characterization of ZnO and Ag/ZnO NCs
2.4. Evaluation of the Antibacterial Activity of ZnO and Ag/ZnO NCs
2.5. In Vitro Cytotoxicity Assay
2.5.1. Cell Culture
2.5.2. MTT Assay
2.6. Photocatalytic Degradation of Methylene Blue Using ZnO and Ag/ZnO NCs
3. Results and Discussion
3.1. Mechanism of Biological Synthesis of ZnO and Ag/ZnO NCs
3.2. Characterization of Biosynthesized ZnO and Ag/ZnO NCs
3.3. Applications of Biosynthesized ZnO and Ag/ZnO NCs
3.3.1. Antibacterial Assay
3.3.2. Photocatalytic Degradation
3.3.3. In Vitro Cytotoxicity Assay
4. Conclusions
Supplementary Materials
Author Contributions
Funding
Data Availability Statement
Acknowledgments
Conflicts of Interest
References
- Sharwani, A.A.; Narayanan, K.B.; Khan, M.E.; Han, S.S. Photocatalytic degradation activity of goji berry extract synthesized silver-loaded mesoporous zinc oxide (Ag@ ZnO) nanocomposites under simulated solar light irradiation. Sci. Rep. 2022, 12, 10017. [Google Scholar] [CrossRef]
- Castro, A.M.; Nogueira, V.; Lopes, I.; Rocha-Santos, T.; Pereira, R. Evaluation of the potential toxicity of effluents from the textile industry before and after treatment. Appl. Sci. 2019, 9, 3804. [Google Scholar] [CrossRef]
- Cova, T.F.; Pais, A.A.; Seixas de Melo, J.S. Reconstructing the historical synthesis of mauveine from Perkin and Caro: Procedure and details. Sci. Rep. 2017, 7, 6806. [Google Scholar] [CrossRef] [PubMed]
- Perkin, W. Producing a New Coloring Matter for Dyeing with a Lilac or Purple Color Stuffs of Silk, Cotton, Wool, or other Materials. Patent BP1984 1856. [Google Scholar]
- Mondal, S.; Samanta, G.; De la Sen, M. Dynamics of Oxygen-Plankton Model with Variable Zooplankton Search Rate in Deterministic and Fluctuating Environments. Mathematics 2022, 10, 1641. [Google Scholar] [CrossRef]
- Kasperchik, V.; Yaskevich, A.; Bil’Dyukevich, A. Wastewater treatment for removal of dyes by coagulation and membrane processes. Pet. Chem. 2012, 52, 545–556. [Google Scholar] [CrossRef]
- Zhang, J.; Wang, F.; Yalamarty, S.S.K.; Filipczak, N.; Jin, Y.; Li, X. Nano silver-induced toxicity and associated mechanisms. Int. J. Nanomed. 2022, 17, 1851–1864. [Google Scholar] [CrossRef] [PubMed]
- Chandran, H.; Meena, M.; Sharma, K. Microbial biodiversity and bioremediation assessment through omics approaches. Front. Environ. Chem. 2020, 1, 570326. [Google Scholar] [CrossRef]
- Patel, H.; Yadav, V.K.; Yadav, K.K.; Choudhary, N.; Kalasariya, H.; Alam, M.M.; Gacem, A.; Amanullah, M.; Ibrahium, H.A.; Park, J.-W. A recent and systemic approach towards microbial biodegradation of dyes from textile industries. Water 2022, 14, 3163. [Google Scholar] [CrossRef]
- Talha, M.A.; Goswami, M.; Giri, B.; Sharma, A.; Rai, B.; Singh, R. Bioremediation of Congo red dye in immobilized batch and continuous packed bed bioreactor by Brevibacillus parabrevis using coconut shell bio-char. Bioresour. Technol. 2018, 252, 37–43. [Google Scholar] [CrossRef]
- Narayanan, K.B.; Sakthivel, N. Biological synthesis of metal nanoparticles by microbes. Adv. Colloid Interface Sci. 2010, 156, 1–13. [Google Scholar] [CrossRef]
- Narayanan, K.B.; Sakthivel, N. Green synthesis of biogenic metal nanoparticles by terrestrial and aquatic phototrophic and heterotrophic eukaryotes and biocompatible agents. Adv. Colloid Interface Sci. 2011, 169, 59–79. [Google Scholar] [CrossRef] [PubMed]
- Kumari, G.; Kamarudheen, R.; Zoethout, E.; Baldi, A. Photocatalytic surface restructuring in individual silver nanoparticles. ACS Catal. 2021, 11, 3478–3486. [Google Scholar] [CrossRef] [PubMed]
- Chen, H.; Liu, C.; Wang, M.; Zhang, C.; Luo, N.; Wang, Y.; Abroshan, H.; Li, G.; Wang, F. Visible light gold nanocluster photocatalyst: Selective aerobic oxidation of amines to imines. ACS Catal. 2017, 7, 3632–3638. [Google Scholar] [CrossRef]
- Widiyandari, H.; Ketut Umiati, N.A.; Dwi Herdianti, R. Synthesis and photocatalytic property of Zinc Oxide (ZnO) fine particle using flame spray pyrolysis method. J. Phys. Conf. Ser. 2018, 1025, 012004. [Google Scholar] [CrossRef]
- Sudhaik, A.; Raizada, P.; Rangabhashiyam, S.; Singh, A.; Nguyen, V.-H.; Van Le, Q.; Khan, A.A.P.; Hu, C.; Huang, C.-W.; Ahamad, T. Copper sulfides based photocatalysts for degradation of environmental pollution hazards: A review on the recent catalyst design concepts and future perspectives. Surf. Interfaces 2022, 33, 102182. [Google Scholar] [CrossRef]
- Li, Z.; Meng, X. Recent development on palladium enhanced photocatalytic activity: A review. J. Alloys Compd. 2020, 830, 154669. [Google Scholar] [CrossRef]
- Ma, C.M.; Lee, Y.W.; Hong, G.B.; Shie, J.L.; Chang, C.T. Effect of platinum on the photocatalytic degradation of chlorinated organic compound. J. Environ. Sci. 2011, 23, 687–692. [Google Scholar] [CrossRef]
- Akshatha, S.; Sreenivasa, S.; Kumar, K.Y.; Archana, S.; Prashanth, M.; Prasanna, B.; Chakraborty, P.; Krishnaiah, P.; Raghu, M.; Alrobei, H. Rutile, mesoporous ruthenium oxide decorated graphene oxide as an efficient visible light driven photocatalyst for hydrogen evolution reaction and organic pollutant degradation. Mater. Sci. Semicond. Process. 2020, 116, 105156. [Google Scholar] [CrossRef]
- Mao, T.; Liu, M.; Lin, L.; Cheng, Y.; Fang, C. A Study on Doping and Compound of Zinc Oxide Photocatalysts. Polymers 2022, 14, 4484. [Google Scholar] [CrossRef]
- Harish, S.; Archana, J.; Sabarinathan, M.; Navaneethan, M.; Nisha, K.; Ponnusamy, S.; Muthamizhchelvan, C.; Ikeda, H.; Aswal, D.; Hayakawa, Y. Controlled structural and compositional characteristic of visible light active ZnO/CuO photocatalyst for the degradation of organic pollutant. Appl. Surf. Sci. 2017, 418, 103–112. [Google Scholar] [CrossRef]
- Yu, C.; Yang, K.; Xie, Y.; Fan, Q.; Jimmy, C.Y.; Shu, Q.; Wang, C. Novel hollow Pt-ZnO nanocomposite microspheres with hierarchical structure and enhanced photocatalytic activity and stability. Nanoscale 2013, 5, 2142–2151. [Google Scholar] [CrossRef]
- Kareem, M.; Bello, I.; Shittu, H.; Sivaprakash, P.; Adedokun, O.; Arumugam, S. Synthesis, characterization, and photocatalytic application of silver doped zinc oxide nanoparticles. Clean. Mater. 2022, 3, 100041. [Google Scholar] [CrossRef]
- Roy, T.S.; Akter, S.; Fahim, M.R.; Gafur, M.A.; Ferdous, T. Incorporation of Ag-doped ZnO nanorod through graphite hybridization: Effective approach for degradation of ciprofloxacin. Heliyon 2023, 9, e13130. [Google Scholar] [CrossRef] [PubMed]
- Mousavi-Kouhi, S.M.; Beyk-Khormizi, A.; Amiri, M.S.; Mashreghi, M.; Yazdi, M.E.T. Silver-zinc oxide nanocomposite: From synthesis to antimicrobial and anticancer properties. Ceram. Int. 2021, 47, 21490–21497. [Google Scholar] [CrossRef]
- Rafique, S.; Bashir, S.; Akram, R.; Jawaid, S.; Bashir, M.; Aftab, A.; Attique, A.; Awan, S.U. In vitro anticancer activity and comparative green synthesis of ZnO/Ag nanoparticles by moringa oleifera, mentha piperita, and citrus lemon. Ceram. Int. 2023, 49, 5613–5620. [Google Scholar] [CrossRef]
- D’Souza, J.N.; Prabhu, A.; Nagaraja, G.; Navada, M.; Kouser, S.; Manasa, D. Unravelling the human triple negative breast cancer suppressive activity of biocompatible zinc oxide nanostructures influenced by Vateria indica (L.) fruit phytochemicals. Mater. Sci. Eng. C 2021, 122, 111887. [Google Scholar] [CrossRef]
- Zhang, T.; Du, E.; Liu, Y.; Cheng, J.; Zhang, Z.; Xu, Y.; Qi, S.; Chen, Y. Anticancer effects of zinc oxide nanoparticles through altering the methylation status of histone on bladder cancer cells. Int. J. Nanomed. 2020, 15, 1457–1468. [Google Scholar] [CrossRef]
- Narayanan, K.B.; Choi, S.M.; Han, S.S. Biofabrication of Lysinibacillus sphaericus-reduced graphene oxide in three-dimensional polyacrylamide/carbon nanocomposite hydrogels for skin tissue engineering. Colloids Surf. B Biointerfaces 2019, 181, 539–548. [Google Scholar] [CrossRef]
- Narayanan, K.B.; Park, G.T.; Han, S.S. Antibacterial properties of starch-reduced graphene oxide–polyiodide nanocomposite. Food Chem. 2021, 342, 128385. [Google Scholar] [CrossRef]
- Singh, A.; Singh, N.á.; Afzal, S.; Singh, T.; Hussain, I. Zinc oxide nanoparticles: A review of their biological synthesis, antimicrobial activity, uptake, translocation and biotransformation in plants. J. Mater. Sci. 2018, 53, 185–201. [Google Scholar] [CrossRef]
- Jain, D.; Shivani; Bhojiya, A.A.; Singh, H.; Daima, H.K.; Singh, M.; Mohanty, S.R.; Stephen, B.J.; Singh, A. Microbial fabrication of zinc oxide nanoparticles and evaluation of their antimicrobial and photocatalytic properties. Front. Chem. 2020, 8, 778. [Google Scholar] [CrossRef]
- Davaeifar, S.; Modarresi, M.-H.; Mohammadi, M.; Hashemi, E.; Shafiei, M.; Maleki, H.; Vali, H.; Zahiri, H.S.; Noghabi, K.A. Synthesizing, characterizing, and toxicity evaluating of Phycocyanin-ZnO nanorod composites: A back to nature approaches. Colloids Surf. B Biointerfaces 2019, 175, 221–230. [Google Scholar] [CrossRef]
- Singh, B.N.; Rawat, A.K.S.; Khan, W.; Naqvi, A.H.; Singh, B.R. Biosynthesis of stable antioxidant ZnO nanoparticles by Pseudomonas aeruginosa rhamnolipids. PLoS ONE 2014, 9, e106937. [Google Scholar] [CrossRef] [PubMed]
- Kyomuhimbo, H.D.; Michira, I.N.; Mwaura, F.B.; Derese, S.; Feleni, U.; Iwuoha, E.I. Silver–zinc oxide nanocomposite antiseptic from the extract of bidens pilosa. SN Appl. Sci. 2019, 1, 681. [Google Scholar] [CrossRef]
- Mahmudin, L.; Suharyadi, E.; Utomo, A.B.S.; Abraha, K. Influence of stabilizing agent and synthesis temperature on the optical properties of silver nanoparticles as active materials in surface plasmon resonance (SPR) biosensor. In Proceedings of the 3rd International Conference on Advanced Materials Science and Technology (ICAMST 2015), Semarang, Indonesia, 6–7 October 2015; p. 020041. [Google Scholar]
- Jobe, M.C.; Mthiyane, D.M.; Mwanza, M.; Onwudiwe, D.C. Biosynthesis of zinc oxide and silver/zinc oxide nanoparticles from Urginea epigea for antibacterial and antioxidant applications. Heliyon 2022, 8, e12243. [Google Scholar] [CrossRef] [PubMed]
- Fouladi-Fard, R.; Aali, R.; Mohammadi-Aghdam, S.; Mortazavi-derazkola, S. The surface modification of spherical ZnO with Ag nanoparticles: A novel agent, biogenic synthesis, catalytic and antibacterial activities. Arab. J. Chem. 2022, 15, 103658. [Google Scholar] [CrossRef]
- Makuła, P.; Pacia, M.; Macyk, W. How to correctly determine the band gap energy of modified semiconductor photocatalysts based on UV–Vis spectra. J. Phys. Chem. Lett. 2018, 9, 6814–6817. [Google Scholar] [CrossRef]
- Xu, J.-J.; Lu, Y.-N.; Tao, F.-F.; Liang, P.-F.; Zhang, P.-A. ZnO Nanoparticles Modified by Carbon Quantum Dots for the Photocatalytic Removal of Synthetic Pigment Pollutants. ACS Omega 2023, 8, 7845–7857. [Google Scholar] [CrossRef]
- Al-Ariki, S.; Yahya, N.A.; Al-A’nsi, S.a.A.; Jumali, M.H.; Jannah, A.; Abd-Shukor, R. Synthesis and comparative study on the structural and optical properties of ZnO doped with Ni and Ag nanopowders fabricated by sol gel technique. Sci. Rep. 2021, 11, 11948. [Google Scholar] [CrossRef]
- Ren, T.; Baker, H.R.; Poduska, K.M. Optical absorption edge shifts in electrodeposited ZnO thin films. Thin Solid Film. 2007, 515, 7976–7983. [Google Scholar] [CrossRef]
- Arefi, M.R.; Rezaei-Zarchi, S. Synthesis of zinc oxide nanoparticles and their effect on the compressive strength and setting time of self-compacted concrete paste as cementitious composites. Int. J. Mol. Sci. 2012, 13, 4340–4350. [Google Scholar] [CrossRef] [PubMed]
- Saleem, S.; Jameel, M.H.; Rehman, A.; Tahir, M.B.; Irshad, M.I.; Jiang, Z.-Y.; Malik, R.; Hussain, A.A.; ur Rehman, A.; Jabbar, A.H. Evaluation of structural, morphological, optical, and electrical properties of zinc oxide semiconductor nanoparticles with microwave plasma treatment for electronic device applications. J. Mater. Res. Technol. 2022, 19, 2126–2134. [Google Scholar] [CrossRef]
- Saboor, A.; Shah, S.M.; Hussain, H. Band gap tuning and applications of ZnO nanorods in hybrid solar cell: Ag-doped verses Nd-doped ZnO nanorods. Mater. Sci. Semicond. Process. 2019, 93, 215–225. [Google Scholar] [CrossRef]
- Dasari, M.P.; Godavarti, U.; Mote, V. Structural, morphological, magnetic and electrical properties of Ni-doped ZnO nanoparticles synthesized by co-precipitation method. Process. Appl. Ceram. 2018, 12, 100–110. [Google Scholar] [CrossRef]
- Elhamdi, I.; Souissi, H.; Taktak, O.; Elghoul, J.; Kammoun, S.; Dhahri, E.; Costa, B.F. Experimental and modeling study of ZnO: Ni nanoparticles for near-infrared light emitting diodes. RSC Adv. 2022, 12, 13074–13086. [Google Scholar] [CrossRef]
- Bonifácio, M.A.R.; Lira, H.d.L.; Neiva, L.S.; Kiminami, R.H.; Gama, L. Nanoparticles of ZnO doped with Mn: Structural and morphological characteristics. Mater. Res. 2017, 20, 1044–1049. [Google Scholar] [CrossRef]
- Sajjad, M.; Ullah, I.; Khan, M.; Khan, J.; Khan, M.Y.; Qureshi, M.T. Structural and optical properties of pure and copper doped zinc oxide nanoparticles. Results Phys. 2018, 9, 1301–1309. [Google Scholar] [CrossRef]
- Riza, M.A.; Go, Y.I.; Harun, S.W.; Anas, S.B.A. Effect of additive concentration on crystalline surface of ZnO nanostructures morphology for enhanced humidity sensing. Sens. Int. 2023, 4, 100211. [Google Scholar] [CrossRef]
- Ismail, A.; Menazea, A.; Kabary, H.A.; El-Sherbiny, A.; Samy, A. The influence of calcination temperature on structural and antimicrobial characteristics of zinc oxide nanoparticles synthesized by Sol–Gel method. J. Mol. Struct. 2019, 1196, 332–337. [Google Scholar] [CrossRef]
- Blount, P.; Marder, L.; Oyegoke, J.; Trad, T. The effects of copper doping on morphology and room-temperature photoluminescence of ZnO nanocolumns. RSC Adv. 2022, 12, 32667–32672. [Google Scholar] [CrossRef]
- Kothe, L.; Albert, M.; Meier, C.; Wagner, T.; Tiemann, M. Stimulation and Enhancement of Near-Band-Edge Emission in Zinc Oxide by Distributed Bragg Reflectors. Adv. Mater. Interfaces 2022, 9, 2102357. [Google Scholar] [CrossRef]
- Gupta, J.; Mohapatra, J.; Bahadur, D. Visible light driven mesoporous Ag-embedded ZnO nanocomposites: Reactive oxygen species enhanced photocatalysis, bacterial inhibition and photodynamic therapy. Dalton Trans. 2017, 46, 685–696. [Google Scholar] [CrossRef] [PubMed]
- Vanheusden, K.; Warren, W.; Seager, C.; Tallant, D.; Voigt, J.; Gnade, B. Mechanisms behind green photoluminescence in ZnO phosphor powders. J. Appl. Phys. 1996, 79, 7983–7990. [Google Scholar] [CrossRef]
- Zheng, Y.; Chen, C.; Zhan, Y.; Lin, X.; Zheng, Q.; Wei, K.; Zhu, J. Photocatalytic activity of Ag/ZnO heterostructure nanocatalyst: Correlation between structure and property. J. Phys. Chem. C 2008, 112, 10773–10777. [Google Scholar] [CrossRef]
- Álvarez-Chimal, R.; García-Pérez, V.I.; Álvarez-Pérez, M.A.; Tavera-Hernández, R.; Reyes-Carmona, L.; Martínez-Hernández, M.; Arenas-Alatorre, J.Á. Influence of the particle size on the antibacterial activity of green synthesized zinc oxide nanoparticles using Dysphania ambrosioides extract, supported by molecular docking analysis. Arab. J. Chem. 2022, 15, 103804. [Google Scholar] [CrossRef]
- Menichetti, A.; Mavridi-Printezi, A.; Mordini, D.; Montalti, M. Effect of Size, Shape and Surface Functionalization on the Antibacterial Activity of Silver Nanoparticles. J. Funct. Biomater. 2023, 14, 244. [Google Scholar] [CrossRef]
- Singh, R.; Cheng, S.; Singh, S. Oxidative stress-mediated genotoxic effect of zinc oxide nanoparticles on Deinococcus radiodurans. 3 Biotech 2020, 10, 66. [Google Scholar] [CrossRef]
- Yu, Z.; Li, Q.; Wang, J.; Yu, Y.; Wang, Y.; Zhou, Q.; Li, P. Reactive oxygen species-related nanoparticle toxicity in the biomedical field. Nanoscale Res. Lett. 2020, 15, 115. [Google Scholar] [CrossRef]
- Dao, T.D.; Han, G.; Arai, N.; Nabatame, T.; Wada, Y.; Hoang, C.V.; Aono, M.; Nagao, T. Plasmon-mediated photocatalytic activity of wet-chemically prepared ZnO nanowire arrays. Phys. Chem. Chem. Phys. 2015, 17, 7395–7403. [Google Scholar] [CrossRef]
- Alharthi, F.A.; Alghamdi, A.A.; Al-Zaqri, N.; Alanazi, H.S.; Alsyahi, A.A.; Marghany, A.E.; Ahmad, N. Facile one-pot green synthesis of Ag–ZnO Nanocomposites using potato peeland their Ag concentration dependent photocatalytic properties. Sci. Rep. 2020, 10, 20229. [Google Scholar] [CrossRef]
- Essawy, A.A. Silver imprinted zinc oxide nanoparticles: Green synthetic approach, characterization and efficient sunlight-induced photocatalytic water detoxification. J. Clean. Prod. 2018, 183, 1011–1020. [Google Scholar] [CrossRef]
- Kumar, A.; Sharma, G.; Naushad, M.; Singh, P.; Kalia, S. Polyacrylamide/Ni0.02Zn0.98O nanocomposite with high solar light photocatalytic activity and efficient adsorption capacity for toxic dye removal. Ind. Eng. Chem. Res. 2014, 53, 15549–15560. [Google Scholar] [CrossRef]
- Ha, L.P.P.; Vinh, T.H.T.; Thuy, N.T.B.; Thi, C.M.; Viet, P.V. Visible-light-driven photocatalysis of anisotropic silver nanoparticles decorated on ZnO nanorods: Synthesis and characterizations. J. Environ. Chem. Eng. 2021, 9, 105103. [Google Scholar] [CrossRef]
- Chiu, Y.-H.; Chang, K.-D.; Hsu, Y.-J. Plasmon-mediated charge dynamics and photoactivity enhancement for Au-decorated ZnO nanocrystals. J. Mater. Chem. A 2018, 6, 4286–4296. [Google Scholar] [CrossRef]
- Zhang, C.; Kong, C.; Tratnyek, P.G.; Qin, C. Generation of reactive oxygen species and degradation of pollutants in the Fe2+/O2/tripolyphosphate system: Regulated by the concentration ratio of Fe2+ and tripolyphosphate. Environ. Sci. Technol. 2022, 56, 4367–4376. [Google Scholar] [CrossRef] [PubMed]
- Sukhanova, A.; Bozrova, S.; Sokolov, P.; Berestovoy, M.; Karaulov, A.; Nabiev, I. Dependence of nanoparticle toxicity on their physical and chemical properties. Nanoscale Res. Lett. 2018, 13, 44. [Google Scholar] [CrossRef]
- Khorrami, S.; Zarrabi, A.; Khaleghi, M.; Danaei, M.; Mozafari, M. Selective cytotoxicity of green synthesized silver nanoparticles against the MCF-7 tumor cell line and their enhanced antioxidant and antimicrobial properties. Int. J. Nanomed. 2018, 13, 8013. [Google Scholar] [CrossRef]
- Rohde, M.M.; Snyder, C.M.; Sloop, J.; Solst, S.R.; Donati, G.L.; Spitz, D.R.; Furdui, C.M.; Singh, R. The mechanism of cell death induced by silver nanoparticles is distinct from silver cations. Part. Fibre Toxicol. 2021, 18, 37. [Google Scholar] [CrossRef]
- Hussain, A.; Oves, M.; Alajmi, M.F.; Hussain, I.; Amir, S.; Ahmed, J.; Rehman, M.T.; El-Seedi, H.R.; Ali, I. Biogenesis of ZnO nanoparticles using Pandanus odorifer leaf extract: Anticancer and antimicrobial activities. RSC Adv. 2019, 9, 15357–15369. [Google Scholar] [CrossRef]
- Chandrasekaran, S.; Anusuya, S.; Anbazhagan, V. Anticancer, anti-diabetic, antimicrobial activity of zinc oxide nanoparticles: A comparative analysis. J. Mol. Struct. 2022, 1263, 133139. [Google Scholar] [CrossRef]
- Tanino, R.; Amano, Y.; Tong, X.; Sun, R.; Tsubata, Y.; Harada, M.; Fujita, Y.; Isobe, T. Anticancer activity of ZnO nanoparticles against human small-cell lung cancer in an orthotopic mouse Model ZnO nanoparticles inhibit growth of small-cell lung cancer. Mol. Cancer Ther. 2020, 19, 502–512. [Google Scholar] [CrossRef] [PubMed]
- González, S.E.; Bolaina-Lorenzo, E.; Pérez-Trujillo, J.; Puente-Urbina, B.; Rodríguez-Fernández, O.; Fonseca-García, A.; Betancourt-Galindo, R. Antibacterial and anticancer activity of ZnO with different morphologies: A comparative study. 3 Biotech 2021, 11, 68. [Google Scholar] [CrossRef] [PubMed]
- Wang, H.; Xing, Z.; Sun, Y.; Jing, Y.; Zhang, J.; Li, X.; Zhang, H.; Shakoor, A.; Guo, J. UV-irradiating synthesis of cyclodextrin–silver nanocluster decorated TiO2 nanoparticles for photocatalytic enhanced anticancer effect on HeLa cancer cells. Front. Chem. 2022, 10, 995261. [Google Scholar] [CrossRef] [PubMed]
- Tenjin, T.; Yoshino, N.; Tanaka, S. Evaluation of cell viability by double-staining fluorescence assay. Gan Kagaku Ryoho Cancer Chemother. 2002, 29, 2025–2029. [Google Scholar]
- Cai, D.; Gao, W.; Li, Z.; Zhang, Y.; Xiao, L.; Xiao, Y. Current development of nano-drug delivery to target macrophages. Biomedicines 2022, 10, 1203. [Google Scholar] [CrossRef]

Disclaimer/Publisher’s Note: The statements, opinions and data contained in all publications are solely those of the individual author(s) and contributor(s) and not of MDPI and/or the editor(s). MDPI and/or the editor(s) disclaim responsibility for any injury to people or property resulting from any ideas, methods, instructions or products referred to in the content. |
© 2023 by the authors. Licensee MDPI, Basel, Switzerland. This article is an open access article distributed under the terms and conditions of the Creative Commons Attribution (CC BY) license (https://creativecommons.org/licenses/by/4.0/).
Share and Cite
Narayanan, K.B.; Bhaskar, R.; Seok, Y.J.; Han, S.S. Photocatalytic Degradation, Anticancer, and Antibacterial Studies of Lysinibacillus sphaericus Biosynthesized Hybrid Metal/Semiconductor Nanocomposites. Microorganisms 2023, 11, 1810. https://doi.org/10.3390/microorganisms11071810
Narayanan KB, Bhaskar R, Seok YJ, Han SS. Photocatalytic Degradation, Anticancer, and Antibacterial Studies of Lysinibacillus sphaericus Biosynthesized Hybrid Metal/Semiconductor Nanocomposites. Microorganisms. 2023; 11(7):1810. https://doi.org/10.3390/microorganisms11071810
Chicago/Turabian StyleNarayanan, Kannan Badri, Rakesh Bhaskar, Yong Joo Seok, and Sung Soo Han. 2023. "Photocatalytic Degradation, Anticancer, and Antibacterial Studies of Lysinibacillus sphaericus Biosynthesized Hybrid Metal/Semiconductor Nanocomposites" Microorganisms 11, no. 7: 1810. https://doi.org/10.3390/microorganisms11071810
APA StyleNarayanan, K. B., Bhaskar, R., Seok, Y. J., & Han, S. S. (2023). Photocatalytic Degradation, Anticancer, and Antibacterial Studies of Lysinibacillus sphaericus Biosynthesized Hybrid Metal/Semiconductor Nanocomposites. Microorganisms, 11(7), 1810. https://doi.org/10.3390/microorganisms11071810

